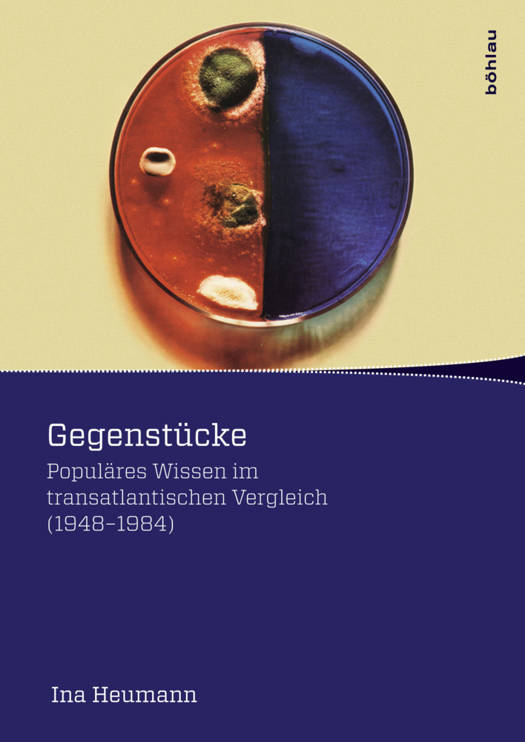

- Afhalen na 1 uur in een winkel met voorraad
- Gratis thuislevering in België vanaf € 30
- Ruim aanbod met 7 miljoen producten
- Afhalen na 1 uur in een winkel met voorraad
- Gratis thuislevering in België vanaf € 30
- Ruim aanbod met 7 miljoen producten
Zoeken
€ 109,95
+ 219 punten
Omschrijving
"Gegenstucke" erzahlt eine faszinierende Geschichte popularer Wissenskommunikation im transatlantischen Vergleich von der Nachkriegszeit bis in die 1980er Jahre. Das Buch konzentriert sich auf zwei herausragende Beispiele des Genres - die Zeitschrift Bild der Wissenschaft sowie ihr Vorbild Scientific American. Anhand einer mikroskopischen und dichten Beschreibung von Bildern, Texten, Inhalten, Akteuren und Netzwerken, die beide Zeitschriften charakterisierten und hervorbrachten, zeigt das Buch, dass populare Wissenskommunikation von ihren nationalpolitischen, mentalitatsgeschichtlichen, sozialen, werbewirtschaftlichen, bildhistorischen und kollektivbiografischen Kontexten gesattigt ist und sie zu je eigenen Stilen der Wissenskommunikation verarbeitet. Ausgezeichnet mit dem Forderpreis der Deutschen Gesellschaft fur die Geschichte der Medizin, Naturwissenschaft und Technik (2011).
Specificaties
Betrokkenen
- Auteur(s):
- Uitgeverij:
Inhoud
- Aantal bladzijden:
- 391
- Taal:
- Duits
- Reeks:
- Reeksnummer:
- nr. 4
Eigenschappen
- Productcode (EAN):
- 9783205795117
- Verschijningsdatum:
- 28/10/2014
- Uitvoering:
- Paperback
- Formaat:
- Trade paperback (VS)
- Afmetingen:
- 170 mm x 239 mm
- Gewicht:
- 765 g

Alleen bij Standaard Boekhandel
+ 219 punten op je klantenkaart van Standaard Boekhandel
Beoordelingen
We publiceren alleen reviews die voldoen aan de voorwaarden voor reviews. Bekijk onze voorwaarden voor reviews.